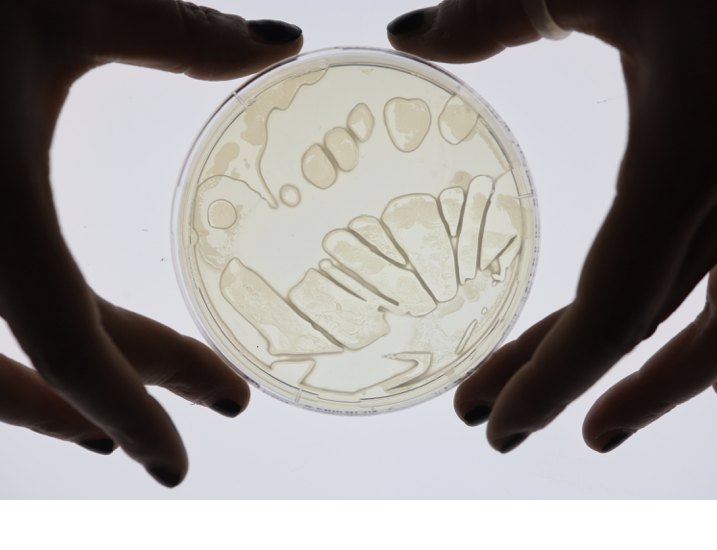

RESEARCH PROJECTS
STEAM/INC New Interdisciplinary Methods, A research project in Partnership with UAL, Arts Electronica and Erasmus+
In April 2021, The Illustration programme at Camberwell College of Arts hosted a one- day online symposium “Remote Sensing”. Speakers were members of the UAL academic community and invited guests from national and International institutions. The publication contains documentations of the symposium, including transcripts, expanded abstracts, discussions, images and sound.The work I presented was part of a seven-weeks projects, delivered in Spring 2021, aimed to explore the nature of a ‘site’-in relation to interdisciplinary art and science practice, e.g, working between laboratory, studio and field. Site of Practice explored remote and distributed field work(in the context of digital and situated learning). Through presentations and workshops, the event offered the opportunity to explore new ways of evolving innovative curriculum design and illustrating how STEAM methods could offer effective interdisciplinary approaches to problem solving and design. The STEAM/Inc Erasmus+ project is a partnership made up of six higher educational institutions including Art Electronica, which is a unique worldwide renowned platform of art, technology and society.
Exploring the Field,”The scientific Method” Wimbledon Common Reserve,London 2021.
BIO MOON-LAB
Bio-Moon Lab is growing different living organisms such as algae and bacteria by transforming and processing their growth where Bio-light is the new terminal.Bio Moon Lab is an on -going research project that enquires about future perspectives in the field of bioluminescence as potential and conscious applications within contemporary art practice. Acknowledging the intention to look at alternative sources of sustainable energy to replace artificial forms of light in the context of contemporary art.Light is conceptualised as a creative interface where Speculative experimentations are endorsed to creatively manipulating living organisms as the V.Fisheri bacteria to establish a new bridge of communication between contemporary art and Science within the community. Bio Moon lab has been recently published in the I-Science magazine from the Imperial college, Future Material Bank from Jane Van Eyck Academie and the Conscious Colours Collection from UAL.
I -Science, magazine, Imperial College , 2022
METAMORPHOSIS
Metamorphosis is a solo show displayed at HubArt gallery in Milan in 2021, The exhibition investigated the close relationship between art, nature, and science: where color and movement intersected to generate dynamic and bio art inspired artworks .The exhibition offered the visitor the opportunity to interact and enter within the vibrant and energetic path, where the artist aims to challenge the boundaries of painting by adding light as an external element of research. The artworks on display represented a wide and diversified range of medium used by the artist.Acrylics, drawings, sketches, and multidisciplinary works with neon light.
The scientific and mathematical aspect within the works emerged in particular in the meticulous and precise drawings and sketches, in which trajectories and structures marked the importance of physical and mathematical laws as an indispensable part of the artist’s research. In fact, Laura Benetton’s eye looked at the physical structure of butterflies and birds, at their chromatic spectrum closely connected to movement and light waves.
Metamorphosis represented an interesting opportunity to share and show once again the correlation between art and science by connecting to a large audience of the public by engaging contemporary art from a different angle. Transformation, change, progressive mutation. A creative metamorphosis in which the works are presented during their transition from one state to another of their evolution.